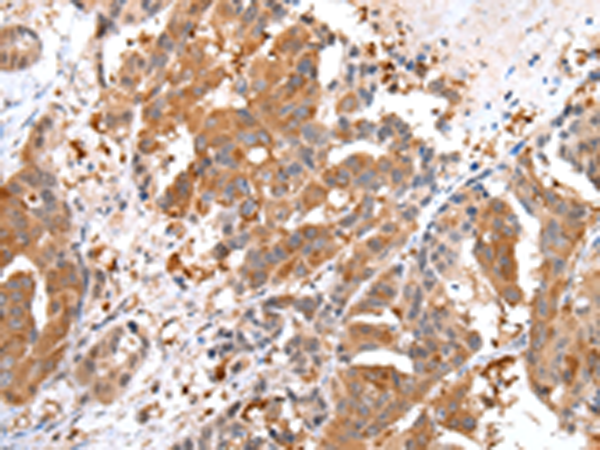
一抗

|
Background: |
The enzyme encoded by this gene is a multifunctional protein. Its main function is to catalyze the synthesis of palmitate from acetyl-CoA and malonyl-CoA, in the presence of NADPH, into long-chain saturated fatty acids. In some cancer cell lines, this protein has been found to be fused with estrogen receptor-alpha (ER-alpha), in which the N-terminus of FAS is fused in-frame with the C-terminus of ER-alpha. |
|
Applications: |
ELISA, IHC |
|
Name of antibody: |
FASN |
|
Immunogen: |
Synthetic peptide of human FASN |
|
Full name: |
fatty acid synthase |
|
Synonyms: |
FAS; OA-519; SDR27X1 |
|
SwissProt: |
P49327 |
|
ELISA Recommended dilution: |
2000-5000 |
|
IHC positive control: |
Human breast cancer |
|
IHC Recommend dilution: |
25-100 |

 購(gòu)物車(chē)
購(gòu)物車(chē) 幫助
幫助
 021-54845833/15800441009
021-54845833/15800441009